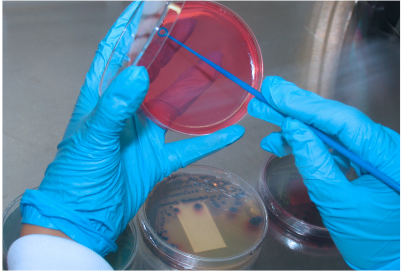
Microbiologico

ANÁLISIS MICROBIOLÓGICO
Areas para análisis de esterilidad (BPL/GLP).
Areas para recuentos no esteriles (BPL/GLP).
Areas para potencias y pruebas especiales (BPL/GLP).
Equipos:
- Cabinas de flujo laminar (new air).
- Autoclave de doble puerta.
- Refrigerador y criostato para mantenimiento de cepas.
- Incubadoras BD, muestreador microbiológico Air Ideal 3p (biomerieux), autoclaves, sistema abierto para análisis de esterilidad (Bomba de vacío + manifold en acero inoxidable), microscopios, entre otros.
Implementación y desarrollo de nuevos métodos según requerimiento del cliente. Portafolio Microbiológico en PDF.
